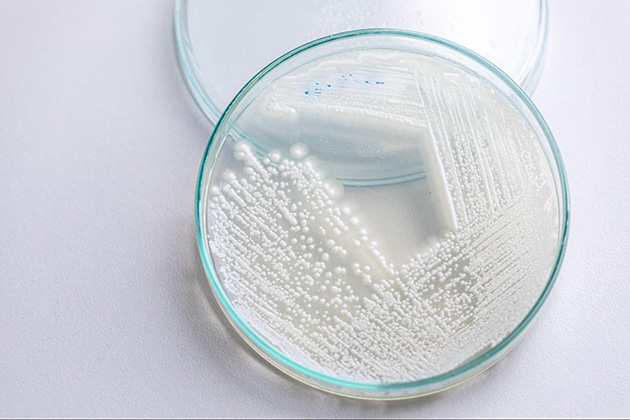
代表 的な産膜酵母ピキア属。白い膜を作る特徴がある。

2024.07
02
日本酒造りと衛生管理の正解を探る(2/2) - 「酒屋万流」と衛生管理
伝統的な日本酒造りにおいて重視されてきた「清潔さ」と、近代的な「食品衛生」の考え方のなかで、酒蔵が向き合うべき衛生管理とはなにかを考えるこの連載。前回は、HACCPの考え方を取り入れた「一般衛生管理」と酒造りの関係を、酒造業界向けのガイドラインをもとに見てきました。
HACCPやそのガイドラインに沿った一般衛生管理は、食中毒を防ぐという観点から、逆算的に体制や仕組みを整備する、というものでした。一方、微生物による食中毒が起きたことがない酒造りにおいては、古くから恐れられてきたのは「腐造」と呼ばれる現象でした。
後編となる今回では、酒造り特有の衛生対策や、個性的な酒造りと衛生性の考え方について紹介していきます。
「腐造」を防ぐための対策
「腐造」 という言葉が指す内容にもさまざまなものがありますが、ここでは「発酵管理や貯蔵管理の不備により、商品として売りものにならない酒ができてしまう現象」を指すこととします。
醸造技術の進歩によって、漫画「もやしもん」で描かれていたような「腐造の原因菌が蔵中に広がり、造る酒すべてが腐って酒蔵が潰れる」といった現象は現代ではほぼなくなりました。
しかし今でも、ちょっとした手違いや知識不足、清掃が行き届かなかった箇所や細かな手抜きの積み重ねから、あるタンクの腐造につながる、というリスクは存在します。
HACCPに沿った一般的な衛生管理によって製造場の清潔さを保っていたとしても、製造方法が誤っていれば腐造は容易に起こります。以下では、代表的な腐造(変調)とその原因を挙げ、対策についてまとめます。
酒蔵でもっとも恐れられる「火落ち」とその原因
腐造と呼ばれるなかでもっとも代表的なものが「火落ち」 です。日本酒のなかで菌が増殖し、混濁、異臭、酸の増加等を引き起こす現象のことを指し、その原因となる複数種の乳酸菌を総称して「火落ち菌」と呼んでいます。

通常の細菌類は、酒内の酸性の環境とアルコールによって増殖できないのですが、火落ち菌の中には度数20%のアルコールにも耐えて増殖するものもいます。
火入れ(63℃で10分以上が標準)によって殺菌をおこなうことができますが、温度が十分でなかったり、容器や採酒時の吞口の洗浄不足、タンク内での侵入などが原因で、火落ちが発生する危険性もあります。酒蔵では腐造の原因として古くから恐れられており、火落ちを予防するための火入れ作業は、酒造りの中で最も衛生に気を遣っておこなわれています。
余談ですが、明治以前には木製容器が用いられており、洗浄しきるのが難しく密閉性も低かったこと、また殺菌方法や知識の十分でなかったために、酒の保管中は定期的に利き酒をおこなって、火落ちの兆候が見られるたびに火入れをおこなう必要がありました。
当時はそもそも微生物の存在すら知られておらず、火落ちが起こりにくい酒のことは「火持ちが良い(火入れの効果が長く続く)」と表現されていました。そのことから「火入れの効果が切れる=火落ち」という言葉が生まれたのではないか、と個人的には推測しています。
火落ちの対策(製成前)
火落ち菌は上槽後に増加する場合が多く、アルコール度数が高いほど、貯蔵温度が低いほど増殖が遅くなります。そのため、もろみや酒の中に菌が存在したとしても、実際に火落ち��が発生するまでにタイムラグが生じ、出荷後に店頭で火落ちが発生するという恐れもあります。
そのため、火落ちの対策としては、まずは衛生管理によって蔵内の火落ち菌のすみかをなくすることが挙げられます。特に、火落ち菌が棲息している場合の多い排水溝や床の水たまりには注意が必要です。そのため、排水溝を清潔に保ち、床を常時乾燥させることが火落ち菌の発生を減らすことに繋がります。
また、火落ち菌の除去に効果のある精密ろ過を取り入れることも有効です。特に、火入れを行わない生酒の場合には、火落ち菌の除去はろ過によっておこなうしかありません。

さらに、ろ過後の瓶詰工程で触れる器具や瓶などに火落ち菌が棲息していた場合、それらが酒の中で増殖し火落ちが起きる危険性があるため、この点にも注意が必要です。ろ過器のフィルターや、火入れ後の酒を輸送するホースや貯酒タンクの吞口、フチなどは念入りに洗浄殺菌をおこなう必要があります。
さらに、火入れの際には温度管理を確実におこなうこと、火入れ後には外部からの火落ち菌の侵入を断つこと(タンク貯蔵時のカバーに穴が空いていないことの確認や、定期的な検酒)などの対策が挙げられます。
火落ちの対策(製成後)
これまで見てきた対策をおこなっても、火落ちが起きてしまうことはあります。したがって貯蔵後も定期的に火落ち菌の検査をおこなうことが望ましい、とされています。テキスト等では1.5ヶ月に1度以上の頻度での検査が推奨されていますが、それより低い頻度だとしても、秋口の初呑み切り以外に、夏前にも検査をおこなっておくことで危険性を減らすことができます。
また、実際に火落ちと疑われる現象が起きた時には、「本当に火落ちなのか」を特定することも必要になります。たとえば、火落ちと似た見た目の現象として「白ぼけ(たんぱく混濁)」があります。これは、お酒の中に残っていた酵素が凝縮したものです。火落ちと区別する方法として、静置しておくと沈殿することや、60℃程度に温めると透明化することが挙げられます。

画像出典リンク:https://o3.hatenablog.jp/entry/2015/07/16/000000
これに該当せず、検査によって火落ち菌が検出された場合は、直ちに再火入れするか、ろ過、火入れ、瓶詰を行い火落ち菌の増殖を最小限にとどめることが大切です。
瓶詰後には低温で保管することで、火落ち菌が残存していた場合でも増殖速度を遅らせるこ��とはできます。ただし、その後の酒販店の管理や販売後の消費者の管理によっては火落ちが発生する可能性もあるので、やはり商品の中に火落ち菌を残さないといったことが原則となるでしょう。
火落ち以外の腐造、変調:腐造乳酸菌によるもの
代表的な「火落ち」以外にも、腐造や変調の原因はあります。たとえば、火落ち菌とは異なる乳酸菌によるものが該当します。原因としては、麹から乳酸菌が持ち込まれるケースが多いですが、仕込み水の汚染や器具用具の洗浄不足による場合もあります。
低精白米や、洗米が不十分な米を短時間蒸しで仕上げて麹米とする場合、原料由来の枯草菌などの雑菌が殺菌しきれず、蒸し米上で麹菌よりも優先して生育する場合があります。あるいは、既に枯草菌や乳酸菌等の雑菌に汚染された麹室では、正常な麹菌の増殖が行われず、糖化力が少なくて雑菌数の多い麹ができあがります。
このような麹を酒母やもろみに用いた場合に、酵母の増殖よりも早く腐造乳酸菌の増殖が行われる可能性があります。腐造乳酸菌に侵された酛やもろみでは、初期段階で香味の異常が発生します。酸臭やヨーグルトのような香りが発生し、酸度が異常に増加して、発酵が停滞したり停止したりします。乳酸菌は小さく、ろ紙を通過するので、乳酸菌が異常に増殖しているもろみの分析ろ液は白く濁った外観となります。
火落ち以外の変調、腐造:野生酵母によるもの
日本酒の世界で「野生酵母」という言葉が使われるとき、おおむね広義の野生酵母と狭義の野生酵母に大別できます。
日本酒(清酒)の発酵に用いられる酵母はS.セレビシエという種類のものです。なかでも日本酒造りに適したものは清酒酵母と呼ばれます。代表的なものとして、日本醸造協会が頒布する「協会〇号酵母」などがあります。

狭義の野生酵母は、S.セレビシエではあるものの、協会酵母などの培養された清酒酵母ではなく、またそれらに比べて日本酒づくりへの適性が劣るようなものを指します。培養酵母では出せない独自の個性を期待して、あえて酵母を添加せずに、あるいは自家採取の酵母を用いて酒造りをおこなう例も増えています。
広義での野生酵母はS.セレビシエ以外の種類、例えばカンジタや産膜酵母などを指します。アルコールの生成能力が低く、酸性かつ高アルコールの環境に耐えられないため、酒造りには向いていない酵母たちです。
もろみの中で増殖している培養酵母と野生酵母の比率は、TTC染色(※)によって判別をおこなうことができます。
(※)TTC染色:トリフェニルテトラゾリウムクロライドが、脱水素酵素によって赤色の TPF(トリフェニルホルマザン)になることを利用した試験。ミトコンドリアの働きの違いにより、培養酵母(きょうかい酵母)の場合には赤色に、野生酵母の場合にはピンク色になる。
火落ち以外の変調、腐造:冷え込み
酒母に添加する酵母が管理時の不備(凍結や高温)で死滅していたり、添加後の品温操作を誤ったり、麹の酵素力価が不十分だった場合などに、添加酵母の増殖が健全に行われず、アルコール発酵が停滞・停止する「冷え込み」が発生する危険性があります。
酵母の増殖が停滞すると、上記のような腐造乳酸菌や野生酵母などの微生物汚染が起こりやすく、香味の劣化や腐造が発生する原因ともなります。
火落ち以外の変調、腐造対策
腐造・変調には、これまで見てきたようにさまざまな原因が考えられます。失敗の原因が明らかな場合を除くと、これらの要因が少しずつ重なり合っていることも多いため、製造工程全�体の見直しが必要になるかもしれません。
特に、もろみの品温が外気温の影響を受けやすい少量仕込みや、酒母省略仕込み、酒質の多様化のための挑戦的な仕込みなどでは注意が必要です。
腐造・変調の兆しが確認された場合には、迅速にその原因を突き止めた上で救済策を打つ必要があります。たとえば、酛の酸度不足なら乳酸添加、麹の酵素が不足した場合には麹や酵素剤の添加などです。
ただし、状況によってはリカバリーが困難な場合もあります。その場合には、関係機関に連絡・相談したうえで、微生物汚染が他のもろみに拡大するのを防ぐ措置をとるなどの善後策を実行する必要があります。
意図しないオフフレーバーを防ぐための注意事項
ここまで、「出荷できない事態」を指す腐造と、衛生管理の関係について解説してきました。しかし、そこまでの事態ではないにしても、衛生管理の状況が日本酒の味わいにマイナスの影響を与えてしまうこともあります。
日本酒のような嗜好品において、好ましくない味や香りのことを「オフフレーバー」と呼びます。一般的にはオフフレーバーをなくす(減らす)ための衛生管理が求められる一方で、そのような味や香りが「蔵の持ち味」とされる個性につながる場合もあります。
ここからは、上記のような複雑な関係のなかで衛生管理をどのように捉えればよいのか考えつつ、酒蔵に求め�られる対策を整理してみます。
そもそも「オフフレーバー」って?
日本酒の製造過程では多種多様な香りや味の成分が作られますが、これらのうち好ましくないものを指すときに「オフフレーバー」という言葉が使われます。しかし、ある香りや味がオフフレーバーなのか、そうでないのかは時代や立場によって、そして究極的には人によって異なります。
特に近年では、 一般にオフフレーバーとされやすい味や香りでも、消費者や酒販店などの評価につながる場合も多くあります。代表的なものとして、従来は日本酒では避けられてきた「酸味」は、近年では甘味とのバランスをとる味わい、あるいは個性を表現する味わいとして評価されるようになってきています。
また、その蔵で歴史的に「持ち味」とされてきた味や香りなど、造り手が表現したい味わいのデザインのなかに、一般的にはオフフレーバーとされやすい味や香りが含まれていることもあります。たとえば「渋味」や、「老ね香」とされるものの一部がこれに該当します。
参考:そもそも日本酒のオフフレーバーとは何なのか?こうした時代や立場による評価とは別に、その香りや味わいが、造り手が意図したものか、そうでないのかという観点もあります。仮に消費者に評価される味わいだとしても、それを持ち味としようとしたときには再現性が求められます。
その味わいや香りの原因や由来がはっきりしているなど、意図して表現可能か、という点は、オフフレーバーと持ち味を区別するための重要な要素となりそうです。「持ち味」となるべき背景や評価がなく、かつ、意図して表現できない香りや味は、基本的にはオフフレーバーとして避けるべきであると考えられます。
このように考えると衛生管理においては、一般的なオフフレーバーの原因物質が、製造の際にどのように発生し酒に影響をあたえているのか、またどのようにコントロールできるのかを理解しておくことが有用でしょう。以下では工程別に発生しやすいオフフレーバーをあげていきます。
麹づくりで発生するオフフレーバー原因物質とその対策:菌数を減らす
麹づくりがおこなわれる麹室は、一般的には外気に対して開放的な環境であるため雑菌の侵入が起こりやすく、また麹室に出入りする人による菌の持ち込みや、器具の連続使用による雑菌の移行など、さまざまなリスクがあります。
先ほど触れた腐造乳酸菌や、酒造りの大敵と恐れられる枯草菌(納豆菌など)は麹を汚染する代表的な雑菌であり、腐造の原因となるほか、強すぎる酸味の原因にもなります。他にも、燻製のような香りや獣臭の原因となる物質・4VGは、麹中で増殖する雑菌によって発生することが知られています。
基本的に、麹製造の際に雑菌が増殖するメリットはほとんどありません。製造工程や衛生管理によって麹の雑菌を減らす対策が重要です。

麹の菌数を減らすためには
細菌汚染を防ぐ原則は、そもそも原料を細菌に触れさせないこと、触れた場合でも細菌が増殖する環境を作らないこと、場内に存在する細菌をやっつけること、です。この考え方にしたがって、麹づくりの工程ごとに、要因と対策を挙げていきます。
まずは蒸し工程。蒸気による加熱殺菌で大半の菌は死滅しますが、芽胞を形成した枯草菌は耐熱性が高く、104℃ 15分加熱でも約1割が生存するとされています。洗米をしっかりおこなうとともに、低精白米の場合や、短時間蒸しの場合には特に注意する必要があります。また、蒸し後の米に触れる放冷機や、布などの洗浄殺菌も重要です。
麹室の中では、床布や麹布、蓋や箱など直接麹に触れる器具の定期的な洗浄殺菌が大切です。酒蔵では日々、麹づくりがおこなわれるため、器具が細菌に汚染されると、それが連鎖してしまう恐れがあります。
道具だけでなく、麹室内のほこりやチリなどから麹への菌の飛び込みも考えられるため、こまめな清掃や空気清浄機の導入などの対策も有効でしょう。造り期間中に麹室が休む機会があれば、拭き上げによる清掃をおこなったうえで、燻蒸消毒、オゾン発生装置、殺菌灯などの使用によって室内の菌数を減らすことができます。

麹製造の際には、作業者からの雑菌の持ち込みも注意する必要があります。原料に素手で触れることも多い麹づくり作業にあたっては、手洗い、消毒は当然のこととして、近年では手袋の使用によって直接麹に触れない製造場も増えています。手袋には微妙な温度の変化を感じにくくなる等のデメリットもありますが、いくら念入りな手洗いをおこなっていても、一定の汚染リスクがあります。
また、手袋をする場合でも、例えばその状態で麹以外のもの(ドアの取っ手や頭髪など)を触ったときに汚れがついたり、作業中に手袋が破れてしまうことで、かえって異物混入や汚染のリスク増える場合もあるかもしれません。米を触る直前に殺菌済みの手袋をつけ、破損に気をつけながら作業をする必要があります。
発酵管理、上槽、ろ過、保管、瓶詰
◆ピルビン酸とαアセト乳酸
ピルビン酸は、酵母がアルコールをつくる過程で生成される成分です。もろみの発酵過程で増加するものの、もろみ後期になると酵母に取り込まれるため減少していきます。
ピルビン酸は、貯蔵中にアセトアルデヒドという、木香様臭と呼ばれるオフフレーバーをつく�る物質に変化します。もろみ中のピルビン酸濃度が高い(100mg/L以上)状態で上槽がおこなわれると、この香りが発生するリスクが高くなります。同じくピルビン酸の濃度が高いもろみにアルコールを添加すると、酵母の作用で急激にピルビン酸からアセトアルデヒドへの転換が起こります。
このほか発酵途中の若いもろみにはαアセト乳酸も多く含まれており、この物質は上槽後にジアセチルに変化してヨーグルトのような香りのオフフレーバーの原因になります。
これらは「若上げ(早い段階で上槽をおこなうこと)」が原因 で発生することが多いオフフレーバーです。こうした上槽をおこなうアルコール度数が低めのお酒などの場合には、注意が必要です。
上槽後にピルビン酸が多く残ってしまった場合には、酵母を添加してピルビン酸の消失を図ったり、活性炭ろ過によって脱臭するといった救済方法もあります。ピルビン酸濃度を調べる検査キットが市販されているので、数値を計測しながら上槽時期を判断することも有効です。

◆DMTS(老香)
DMTSはいわゆる老香(ひねか)の原因物質の一つとされ、単体では漬物の香りなどと表現されます。この物質は、前駆体であるDMT-P1のもろみ中での生成量と、最終的な酒質、そして上槽後の管理によって生成量が変わります。
前駆体であるDMTS‐P1は、酵母の死滅率やもろみ日数、アミノ酸度、米の溶解度と正の相関関係があり、原料米に含まれる硫黄分も関与しているのではないか、という報告もあります。また、上槽時の圧力が高い場合(搾り箇所の「責め」時)にも増加します。
このDMTS‐P1が貯蔵中にDMTSに変化していきます。その変化速度は、保管中の酸素量や保管温度・期間の影響を受けるほか、日本酒に含まれる成分によって増減するともされています。
誤解を恐れずに単純化して言うと、米をしっかり溶かして日本酒度も十分に切らせたいわゆる「荒い酒」で出やすく、米を溶かさない「きれいな酒」では出にくい、と言えそうです。
◆カプロン酸(脂肪酸臭)
吟醸香と呼ばれる、吟醸酒に特有のフルーティな香りの主成分であるカプロン酸エチルは、脂肪酸であるカプロン酸と、エチルアルコールとが化合することによって生成されます。カプロン酸自体は油や樹脂などの香り(ヤギの体臭と表現されることもあります)であり、一般的にはオフフレーバーに分類されます。
もろみ期間中は酵母の働きによってカプロン酸エチルが増加しますが、もろみ後半になって酵母の活性が落ちると、カプロン酸エチルの生成が止まり、逆に分解が始まってカプロン酸が増加する場合があります。そのため上槽時期の遅れが脂肪酸臭の原因となることがあります。
またカプロン酸エチル高生産性酵母の場合、そもそもカプロン酸の生成量が多くなります。揮発性の高いカプロン酸エチルが火入れや貯蔵によって揮発してしまうと、残ったカプロン酸がオフフレーバーの原因になります。そのため香気成分の多い吟醸酒の保管環境は、より慎重に整備する必要があります。
上槽~瓶詰
◆袋香
酒を搾る際に使われる酒袋や圧搾シートで、使用後に付着した成分の酸化や微生物(特にカビ類)の増殖が起こると、次回の上槽時に酒に「袋香」と呼ばれるオフフレーバーの原因となります。袋についた臭いや微生物は除去することが難しく、念入りに殺菌剤で処理してから洗濯し乾燥しても、保管中にカビが増殖してしまうことがあります。
粕はがしと、その後の水洗いによって汚れを除去し、カビの増殖を抑えられる低温(-5℃以下)で袋を保存することが有効です。また、定期的に薬剤浸漬による殺菌脱臭をおこなうことで、袋香は発生しにくくなります。
◆酵母臭
上槽後、袋の目を通り抜けたデンプンや酵素、あるいは酵母や乳酸菌などの微生物によって、日本酒は僅かに白く濁った状態になります。この状態のお酒を静置しておくと、やがて濁りはタンクの底に沈殿し、滓と呼ばれるものになります。
滓が残っている間は、酵素や酵母による発酵がわずかに起こります。ピルビン酸の取り込みや、ジアセチルの還元も起こるので、これらのオフフレーバーが発生した場合には、滓と絡ませることである程度減少させる事ができます。
しかし滓期間が長くなると、酵母が死滅することでアミノ酸度の上昇(特に苦み物質であるアルギニン)や、酵母臭と呼ばれるオフフレーバーが発生することもあります。
◆イソバレルアルデヒド(生老ね香)
生酒の中に含まれるイソアミルアルコールが、酵素によって分解されることでイソバレルアルデヒドが生成されます。また、長期保管されたお酒の中でもストレッカー分解によって生成されて、老香の原因物質の一つとなります。
特に生酒で発生するイソバレルアルデヒドは、ムレ香や生老ね香と呼ばれるオフフレーバーの原因となります。酵素は通常のろ過では取り除けないので、生老ね香の発生を防ぐためには、火入れをおこなって酵素を失活させるか、酵素が働かない温度帯(-5℃以下)で保管することが必要です。
◆TCA(カビ臭)
TCAはきわめて低い濃度でも酒の香味に害を与える、いわゆるカビ臭の原因物質です。木材に含まれるリグニンという成分が、次亜塩素酸ナトリウム等の塩素系殺菌剤の作用によってTCPという前駆体に変換され、それがカビの作用でTCAへと変換されることでカビ臭が生み出されます。
酒蔵の中では木製品が使われる場面が多々あります。蔵自体が木造であることも多いですし、麹蓋や、ぶんじ、櫂なども木製品が現役で使われていたりします。また、輸送用の木製パレットや、段ボールもTCA汚染の原因となります。

TCAは閾値が低いため、ごく僅かな短期間の接触でもカビ臭の原因となります。例えば「大吟醸用に(TCA汚染された)麹蓋を使ったらそこからTCA汚染が起こった」とか、「アルミとラップで蓋をした斗瓶を(TCA汚染された)木製パレットにのせて4日放置したらカビ臭がついた」といった例があります。酒袋などの殺菌に塩素系洗剤を使った場合にカビ臭の原因となるのも前述のとおりです。
塩素系殺菌剤の使用された木製品には、既に前駆体のTCPが含まれているので、TCAに汚染される危険性が常に存在します。木製品には塩素系殺菌剤の使用を厳禁することを徹底し、またTCA汚染されている可能性のある木製品を製造場内に持ち込まないようにすることが重要です。既にカビ臭が発生してしまった場内では、汚染経路箇所を特定するとともに、器具の熱湯消毒や取り換え張替等を実施する必要があります。
◆紙臭・炭臭
ろ過をおこなう際に用いるろ紙の香りが酒に移行し、紙臭というオフフレーバの発生原因となることがあります。カビ臭にやや似た香りですが、TCAが原因でない場合にはろ紙の品質、ろ過方法に注意する必要があります。
また、ろ過時や火入れ時に用いられる活性炭が原因となる炭臭というオフフレー�バーも存在します。使う活性炭の種類により炭臭の出方は異なります。また、炭を多く使った場合には当然炭臭は増えますし、酒自体の香りも活性炭の作用で薄くなるため、かえって炭臭が目立つ危険性があります。
◆鉄着色
日本酒では僅か0.1ppmというきわめて少量の鉄分によって、鉄着色と呼ばれる見た目や香味の異常が発生します。麹の生成する物質と鉄が反応して生成されるフェリクシンという物質が原因であり、通常の方法でのろ過や活性炭処理では取り除けないために、鉄は清酒製造の大敵とされています。
古い水道管や鉄製の給水配管などを使っている場合、配管を通っている際に鉄が溶けだすため鉄着色が発生することがあります。また、SFフィルターの逆洗等に鉄分の混じった水道水を使うと、フィルター部分に鉄が吸着するため、ろ過時にかえって鉄着色の原因となる場合があります。
その他、ホーロータンクのホーロー部分の剥がれなどから鉄分の溶出が発生し、鉄着色の原因となる場合もあります。
瓶詰~保管

◆瓶口のカビ予防
アルコールの作用によって、酒自体にカビが発生することはありません。しかし、瓶詰時に瓶口に酒が付着した場合、酒に含まれるアルコールが揮発して糖分やアミノ酸だけが瓶口に残るために、そこにカビが発生する危険性があります。瓶詰時には瓶口のふき取りを行い、蓋の殺菌消毒をおこなう必要があります。
◆瓶香、日光着色
日本酒は紫外線(特に320~380nmの波長光)の作用を受けると、「日光着色」や「びん香」等と呼ばれる見た目や香味が発生します。強い直射日光の下ではわずか2~3時間で発生すると言われており、室内でも蛍光灯の明かりによって発生することがあります。
瓶の色によって紫外線をどの程度通すかは異なり、特に透明瓶、青瓶、薄緑瓶は紫外線の影響を受けやすいため、注意が必要です。

◆冷蔵庫内移り香
日本酒を保管する冷蔵庫内では、結露や瓶割れによる汚染等が原因で雑菌やカビが繁殖し、異臭が発生する事があります。その臭いが瓶に移ることで(中身の酒自体の風味には影響がなかったとしても)異臭と認識される可能性があります。
汚れが発生した場合には適宜清掃し、また酒を詰め込みすぎず収蔵量を適量(容量の8割以下)に保って、取り扱い説明書に従って定期的なメンテナンスをおこなう必要があります。
まとめ
「個性」や「味わいの再現性」といったテーマには、多くの酒蔵が取り組んでいることと思います。しかし、そもそも原料となる米も農産物である以上、毎年決まった品質で生産できるわけでなく、完全に空調管理された酒蔵でなければ外気温にも造りが左右されます。
また「お酒を造る」と言っても人間が関与できるのは環境を整えるところまでで、そこから先は微生物たちの仕事になります。ある程度のコントロールは可能ですが、完全に思い通りにはなりません。特に、近年再評価されている生酛、山廃、水酛や酵母無添加などの自然を活かす製法では、さらに不確定要素が増えてしまう側面もあるでしょう。
また、一方で近年では、HACCPの義務化をはじめ食品・飲料のリスクに対する社会の評価は厳しくなり続けている傾向があります。こうした状況では、個性の表現とリスク管理のバランスも求められるでしょう。
日本酒の世界では「酒屋万流」というほど多彩な造り方があり、さらに最近ではチャレンジングな造りを手がける酒蔵も増えています。低アルコール化やノンアルコール化の流れもあり、ますます酒蔵ごとの考え方が問われる時代になってくるのかもしれません。
連載:日本酒造りと衛生管理の正解を探る第1回:HACCPと一般衛生管理 第2回:「酒屋万流」と衛生管理
参考文献
- 熊本国税局鑑定官室「野生酵母と乳酸菌による汚染」(日本釀造協會雜誌, 第62巻9号, 1967)
- 公益財団法人 日本醸造協会「増補改訂 清酒製造技術」(日本醸造協会、2016)
- ��野白喜久雄清「醸造微生物学の進歩--清酒醸造微生物学の進歩-4-」(日本釀造協會雜誌, 第79号4巻, 1984)
- 塚本桂子「麹を汚染する抗酵母性細菌」(日本釀造協會雜誌, 77巻9号, 1982)
- 菅野信男「野生酵母による酒母もろみの汚染」(日本釀造協會雜誌, 第62巻9号, 1967)
- Nagi's Wineworld「野生酵母の功罪」(2024年6月26日閲覧)
- 金桶光起「清酒中の4‐ビニルグアイアルコール生成要因」(日本醸造協会誌,第109巻5号, 2014 )
- アサマ化成株式会社「バイキン博士の衛生雑談 食と微生物 22.加熱殺菌-1」(アサマパートナーニュース, No.129, 2009)
- 公益社団法人 日本食品衛生協会「手洗いレベルと汚れ、通過細菌、常在細菌との関係」
- 溝口晴彦「生酛の乳酸菌叢と生酛づくりの品質特性」(日本醸造協会誌, 第108巻6号, 2013)
- 伊藤和樹, 佐藤時習, 兜森忠道, 渡辺�誠衛, 田口隆信「もろみ中のピルビン酸を指標とした発酵管理」(日本醸造協会誌, 第102巻4号, 2007年)
- 佐藤俊一, 水野昭博, 岩野君夫, 高原康生, 木崎康造, 佐野英二, 辻邦司, 梅田紀彦, 戸塚昭, 川島宏「ソフトタイプ清酒醸造におけるピルビン酸の消長」(日本釀造協會雜誌, 第76巻11号, 1981年)
- あいち産業科学技術総合センター食品工業技術センター「技術解説『市販ピルビン酸分析キットの清酒製造工程への適用』」(あいち産業科学技術総合センター食品工業技術センターニュース, 2021年6月号)
- 佐々木慧, 西堀奈穂子, 吉田聡子, 金井宗良, 磯谷敦子, 山田修後, 藤奈美, 藤井力「清酒のジメチルトリスルフィド生成に影響する製造要因の解析」(日本醸造協会誌, 第117巻2号, 2022)
- 西堀菜穂子「老ねにくい清酒の醸造方法」(独立行政法人 酒類総合研究所)
- 磯谷敦子「清酒の品質と香気成分」(第334回ガスクロマトグラフィー研究会発表資料, 2014年12月12日)
- 山根善治「お��答えします 清酒中の脂肪酸が官能評価に与える影響について教えてください。」(日本醸造協会誌, 第93巻8号, 1998)
- 宇田川 俊一「一般食品の汚染カビ」(真菌と真菌症, 第20巻3号, 1979)
- SANKEI NewsReport!「日本酒の品質向上と袋香対策」(2024年6月26日閲覧)
- 藤田晃子「清酒のカビ臭の分析と防止」(独立行政法人 酒類総合研究所)
- 野村佳司, 高橋利郎「清酒の蛍光灯着色」(日本醸造協会誌, 第100巻6号, 2005)
- 東京都保健医療局「プレハブ冷蔵・冷凍庫の衛生管理」(食品衛生通信, 令和2年度2・3月号)
Pickup記事
2021.10.27
話題の記事
人気の記事
2020.06.10
最新の記事
2026.06.23
2026.06.09


















